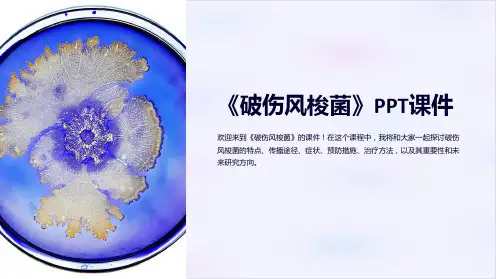

破伤风梭菌资料
- 格式:ppt
- 大小:1014.00 KB
- 文档页数:40



我对破伤风梭菌的认识和了解破伤风梭菌,又称为破伤风杆菌,是一种革兰氏阳性的芽孢杆菌,长约2-8微米,宽约0.4-0.8微米。
它是引起破伤风的主要病原菌,破伤风是一种危险的传染病,主要通过伤口感染引起。
对于破伤风梭菌的认识和了解,有助于预防和治疗破伤风,保障人们的健康。
破伤风梭菌主要存在于土壤、粪便、灰尘等环境中,对高温和干燥具有较高的耐受性。
当人体皮肤或黏膜受伤时,如果被破伤风梭菌侵入,就有可能导致破伤风的发生。
破伤风梭菌产生的毒素可以导致肌肉痉挛和神经系统受损,严重时甚至危及生命。
因此,及时清洁伤口、避免感染是预防破伤风的关键。
破伤风梭菌的特点主要包括芽孢的形成、产生毒素和对环境的耐受性。
芽孢是破伤风梭菌在恶劣环境下形成的一种生存形式,可以在干燥和缺乏营养的环境中存活很长时间,等待适宜的条件再次生长繁殖。
此外,破伤风梭菌还可以产生破伤风毒素,这是引起破伤风症状的主要原因。
这种毒素可以影响神经系统和肌肉,引起肌肉痉挛和僵硬。
针对破伤风梭菌的特点,预防和治疗破伤风的方法主要包括疫苗接种和抗生素治疗。
破伤风疫苗可以有效预防破伤风的发生,建议每10年接种一次破伤风疫苗来保持免疫力。
对于已经感染破伤风的患者,抗生素治疗可以帮助清除体内的病菌,减轻症状和并发症。
总的来说,破伤风梭菌是一种致命的病原菌,引起破伤风的主要原因。
了解破伤风梭菌的特点和传播途径,可以帮助我们采取有效的预防措施,保护自己和他人的健康。
及时接种破伤风疫苗,保持伤口清洁,避免感染是预防破伤风的关键。
在面对破伤风疾病时,及时就医,接受抗生素治疗也是十分重要的。
通过加强对破伤风梭菌的了解和认识,我们可以更好地预防和控制这种危险的疾病。


当你在玩耍或工作时不小心伤到手指,尤其是被尖锐的、生锈的物体所伤后,大多数人可能只是找个纱布包扎一下,很少有人会想到,这看似不起眼的伤口可能会成为一种致命病菌的入口,这种病菌就是破伤风梭菌。
破伤风梭菌的潜在威胁常常会被人们忽视,然而,当它找到合适的入侵机会,带来的后果可能是致命的。
破伤风梭菌的生物学性状破伤风梭菌的菌体细长,长4~8微米,宽0.3~0.5微米,有周鞭毛,能运动。
此外,破伤风梭菌能形成休眠体———芽孢,芽孢呈圆形,位于菌体顶端,直径比菌体宽大,似鼓槌状。
破伤风梭菌的致病性破伤风梭菌虽然尺寸不到10微米,但可以引起一种严重的感染性疾病———破伤风。
破伤风梭菌常通过伤口进入人体内,伤口的厌氧环境是破伤风梭菌感染的重要条件。
破伤风梭菌致病的原因是能产生外毒素———破伤风痉挛毒素或称神经毒素。
这种毒素可以导致严重的神经系统损伤,表现为肌肉僵硬和痉挛,甚至可以导致死亡。
破伤风梭菌的特殊之处在于它的芽孢抵抗力非常强大,在土壤、灰尘和锈蚀的金属表面可长期存在。
这也是为什么我们称其为“铁锈里的隐藏杀手”。
破伤风梭菌的存在通常是不易察觉的,只有当细菌进入人体并繁殖时才可能引发感染。
破伤风梭菌的实验室诊断细菌培养和鉴定破伤风梭菌的培养需要特定的厌氧环境和培养基。
首先,从疑似感染的伤口或组织中取样,将样品置于适当的培养环境中。
经过一段时间的培养后,菌落开始形成。
鉴定破伤风梭菌需要利用其特殊的形态特征和一系列的生化试验。
这些试验包括但不限于:对特定糖的发酵反应、酶的产生以及对某些化学物质的反应。
毒素检测虽然破伤风梭菌的存在是导致破伤风的原因,但真正导致疾病的是它所产生的毒素。
因此,毒素检测是至关重要的。
现有的技术如酶联免疫吸附试验可以检测血清中的毒素。
分子检测聚合酶链式反应(PCR)技术是一种分子生物学技术,用于扩增和检测DNA片段。
对于破伤风梭菌,PCR可以针对其特定的基因进行检测,从而在很短的时间内准确地确认其存在。

•破伤风梭菌(c .tetani)是破伤风的病原菌。
•存在于人和动物的肠道,由粪便污染土壤。
当机体受到外伤时创口被污染,或分娩时用不洁器械剪断脐带等,本菌即可侵入局部创面发芽繁殖,释放毒素引起机体强直性痉挛、抽搐.可因窒息或呼吸衰竭死亡。
如不及时防治,病死率很高。
在发展中国家新生儿破伤风死亡率可高达90%。
••以上原因均可造成有利于破伤风梭菌生长繁殖的厌氧条件。
破伤风梭菌只能在厌氧的局部生长繁殖,细菌不能入血引起菌血症或败血症。
在局部产生的外毒素吸收入血,形成毒血症而发病。
新生儿脐带残端也具备上述厌氧条件.接生时如处理不当也易引起破伤风梭茵的感染,造成新生儿的破伤风,死亡率极高。
••• 2.致病物质•外毒素:破伤风痉挛毒素(tetanospasmin)和破伤风溶血毒素(tetanolysin),前者为主要致病物质。
该毒素对脊髓前角细胞和脑干神经细胞有高度的亲和力,由菌体释放的毒素被局部神经细胞吸收或经淋巴、血液到达中枢神经系统。
毒性极强,对人的致死量小于1ug,仪次于肉毒毒素。
其化学性质为蛋白质,免疫原性强,应用0.3%甲醛作用4周可脱毒制成类毒素,用于人工主动免疫。
破伤风溶血毒素具有溶血作用,在性质、功能和免疫原性上与链球菌溶血素O相似,但在破伤风中的作用尚不清楚。
••3.致病机制破伤风痉挛毒素是由质粒编码表达的,在菌体内为一条分子质量约150 kDa的多肽,分泌到菌体外即被细菌蛋白酶裂解为一条分子质量约50 kDa的轻链(A链)和一条100 kDa的重链(B链),2条肽链之间由二硫键连接,如果没有连接则失去毒性。
其中轻链为毒性部分,重链具有识别受体和转运A链的作用。
重链通过其羧基端识别神经肌肉结点处运动神经元外胞质膜上的受体,与之结合后使毒素进入细胞及其由细胞膜形成的小泡中。
小泡从外周神经末梢沿神经轴突逆行向上,到达运动神纤元细胞体,经过突触后膜进入传入神经末梢,到达脊髓前角运动神经元,再上行至脑干。
破伤风梭菌Cltetani的检验破伤风梭菌大量存在于人和动物肠道中,由粪便污染土壤,是引起人畜破伤风的病原,经伤口感染引起疾病。
具有芽孢,其芽孢广泛存在于各类土壤中。
本病以骨骼肌发生强直性痉挛的症状为特征,此菌也称为强直梭菌。
多自头部肌肉开始痉挛,两耳竖立,鼻孔张大,粘膜外露,头颈伸直,牙关紧闭,腰背伸直,腹部肌肉紧缩,尾根翘起,四肢强直,状如木马,运行极度困难。
1、形态学特性破伤风梭菌菌体细长,长4-8µm,宽0.3-0.5µm ,周身鞭毛,芽胞呈圆形,在动物体内外均能形成,位于菌体顶端,直径比菌体宽大,似鼓槌状,是本菌形态上的特征。
繁殖体为革兰氏阳性,形成芽胞的菌体易转为革兰氏阴性。
2、培养特性破伤风梭菌专性厌氧,最适生长温度为37℃、pH7.0~7.5;普通琼脂平板:24-48h形成直径1mm 以上的不规则菌落,中心紧密,周边疏松,似羽毛状,易在培养基表面迁徒扩散;血液琼脂平板:明显溶血环;疱肉培养基:肉汤浑浊,肉渣部分被消化,微变黑,产生气体,生成甲基硫醇(有腐败臭味)及硫化氢。
3、生化特性与抵抗力生化特性:一般不发酵糖类,能液化明胶,产生硫化氢,形成吲哚,不能还原硝酸盐。
对蛋白质有微弱消化作用。
抵抗力本菌繁殖体抵抗力与其他细菌相似,但芽胞抵抗力强大。
在土壤中可存活数十年,能耐煮沸40-50min。
对青霉素敏感,磺胺类有抑菌作用。
4、致病性破伤风梭菌芽胞广泛分布于自然界中;自然条件下,其易感性为:马>猪、牛、羊、犬,人也易感,禽类及变温动物不易感。
此菌产生两种毒素破伤风痉挛毒素:引起神经兴奋性异常增高和骨骼肌痉挛。
是一种神经毒素,为蛋白质,由十余种氨基酸组成,不耐热,分子量15万,可被肠道蛋白酶破坏,故口服毒素不起作用。
破伤风毒素的毒性非常强烈,仅次于肉毒毒素。
破伤风溶血素:不耐热,对氧敏感,可溶解马及家兔的红细胞,与致病性无关。
5、微生物学诊断取创伤渗出物或坏死组织镜检,或加热80℃经20min 以杀死无芽胞杂菌,接种血液琼脂培养基或疱肉培养基中,在厌氧条件下培养24-48小时,挑选可疑菌落进行鉴定,也可取培养滤液0.1毫升接种小白鼠,作毒力和毒力保护试验。
实验四厌氧菌一、破伤风梭菌、产气荚膜梭菌和肉毒梭菌(一)目的要求1. 掌握破伤风梭菌、产气荚膜梭菌、肉毒梭菌的形态特点、培养特性和鉴别要点。
2. 熟悉破伤风梭菌、产气荚膜梭菌和肉毒梭菌的分离培养过程、鉴别的一般原则和常用方法。
3. 解破伤风梭菌、产气荚膜梭菌和肉毒梭菌的外毒素毒性动物实验。
(二)器材和试剂1.菌种破伤风梭菌、产气荚膜梭菌、肉毒梭菌菌种及其形态示教片。
2.培养基疱肉培养基、血琼脂培养基、牛乳培养基、五糖(葡萄糖、乳糖、麦芽糖、甘露醇、蔗糖)发酵管、牛心脑浸液肉汤与琼脂、脂酶培养基。
卵黄琼脂、溴甲酚紫牛乳培养基。
3. 试剂革兰染色液(一套)、芽胞染色液(石炭酸复红、95%酒精、碱性美蓝)、焦性没食子酸、100g/L氢氧化钾、溴甲酚紫;产气荚膜梭菌抗血清、肉毒梭菌多价抗血清、索氏梭菌抗血清;20g/L尿素L-色氨酸、硝酸盐还原试剂、欧氏试剂、美蓝指示剂。
4. 其他小白鼠、家兔、无菌注射器、无菌吸管、滴管、中、小试管、消毒纱布块;固体石蜡或凡士林、酒精灯、三角架、碘酒、酒精、生理盐水、蒸馏水;剪刀、镊子、玻片、药勺、钯粒;厌氧袋、厌氧罐、离心机、水浴锅等。
(三)步骤和方法1.破伤风棱菌(1)形态观察观察破伤风梭菌示教片,其繁殖体型为革兰阳性细长杆菌,散在排列,芽胞型的芽胞呈正圆形,位于菌体顶端,直径大于菌体,使芽胞和菌体呈鼓槌状;该菌鞭毛为周身鞭毛。
(2)培养物观察破伤风梭菌在疱肉培养基中生长缓慢,厌氧培养2~7天后其生长现象为培养液变混浊,产酸,肉渣部分消化微变黑,有少量气体。
生成的甲基硫醇、H2S等使培养物变臭。
破伤风梭菌在血琼脂平板上形成圆形、扁平的菌落。
菌落中心结实,周边疏松似“羽毛状”。
菌落周围有α溶血环,培养时间延长可变为β溶血环。
(3)生化反应将五糖发酵管与牛乳培养基置水浴锅中加热。
热煮沸10min,迅速冷却。
以无菌吸管吸取破伤风梭菌纯培养物,分别滴加。
于牛乳培养基与五糖发酵管中,接种毕,在液面上加一薄层熔化的石蜡。